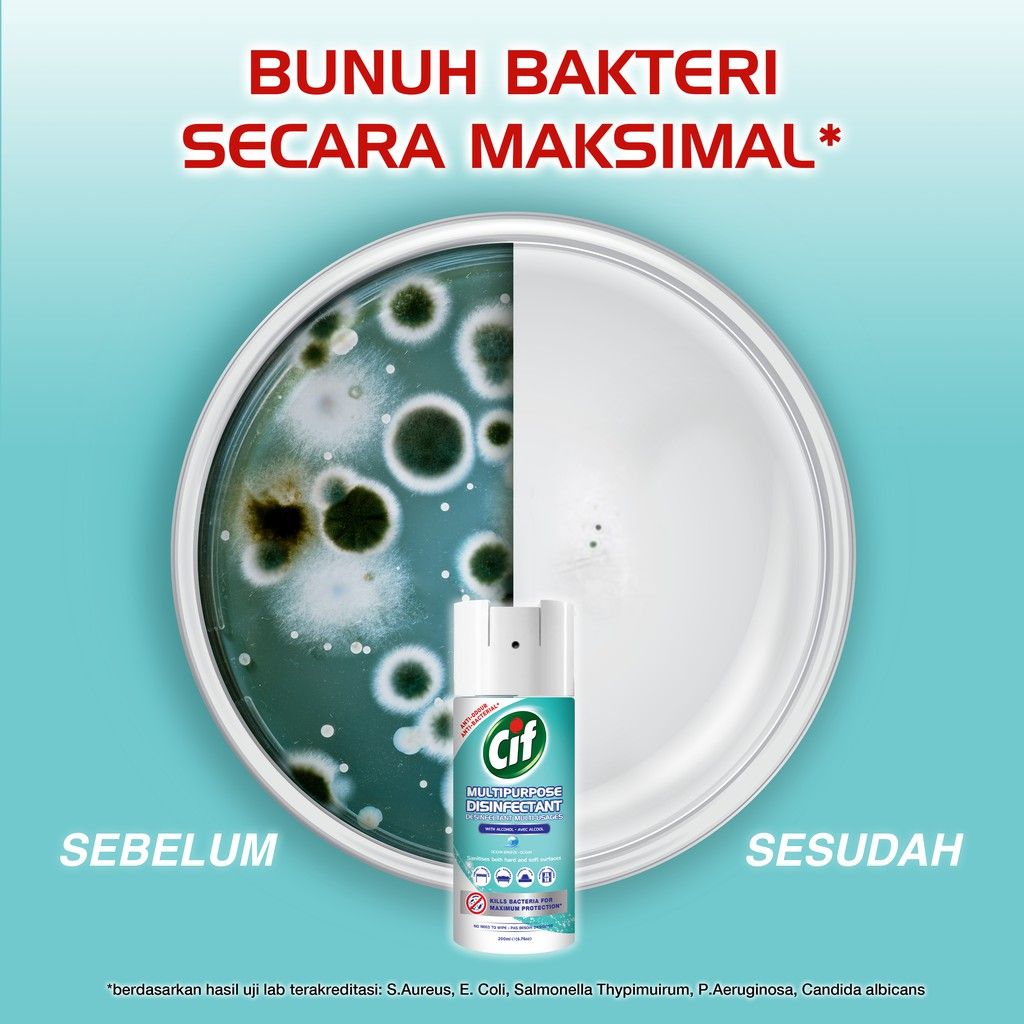
CIF Multipurpose Spray Ocean Breeze 200ml - 3

CIF Multipurpose Spray Ocean Breeze 200ml
Rp76.900
Deskripsi produk
CIF Multipurpose Disinfectant Spray Ocean Breeze 200ml
Ingin mendisinfeksi rumah Anda dengan cara yang efisien dan mudah? Gunakan Cif Multipurpose Disinfectant Spray! Semprotan aerosol ringan multiguna ini secara efektif membunuh bakteri dan virus* secara maksimal pada permukaan keras dan lunak di sekitar rumah Anda untuk menjaga Anda dan orang yang Anda cintai tetap aman. Dengan keharuman Ocean Breeze, dapat menyegarkan dan menghilangkan alergen di udara. Cif Multipurpose Disinfectant Spray tidak meninggalkan residu dan tidak perlu dibilas atau lap, sehingga Anda dapat mendisinfeksi tanpa menghabiskan waktu dan energi ekstra. Teruji secara dermatologis sehingga aman jika terkena kulit. Di Cif, kami percaya dalam mengungkapkan dan melindungi keindahan untuk dinikmati semua orang, setiap hari. Itulah sebabnya selama lebih dari 50 tahun, Cif telah mengembangkan rangkaian produk pembersih yang menghilangkan kotoran jelek, tanpa merusak permukaan memberikan Anda hasil yang indah. *berdasarkan hasil uji lab terakreditasi: S.Aureus, E. Coli, Salmonella Thypimuirum, P.Aeruginosa, Candida albicans." Perlindungan maksimal lawan bakteri All-in-1 disinfectant: membunuh bakteri, menyegarkan udara dan menghilangkan alergen tanpa meninggalkan residu dan tidak perlu dibilas atau dilap. Cocok untuk permukaan keras dan lunak, seperti meja, sofa, toilet. Tidak meninggalkan noda.
Isi Paket
- 1 x CIF Multipurpose Spray Ocean Breeze 200ml